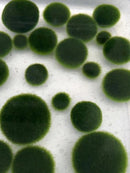
Must-have Large 1.5cm Marimo Moss Ball - Round and Grow Slow

Items adding...
Enhance your order with these recommended add-ons.
Description
Buy 3 Get 1 Free
Buy 5 Get 2 Free
In exploding period or close to. In exploding period, Marimo Moss Balls are on a 99% survive rate. Our products here accept 30 days free replacement if died.


The right side is about 1.5-1.8cm.
It is Japanese marimo moss ball that slow growing.
This is exactly the same type of marimo. Taking 50 years to go big:




It's this:

This:


Not this:
 Not this:
Not this:

Not this:

Simply, this type of marimo needs 20 years from 1cm to 8cm.
For algae type of marimo needs only about 5 years to go from 1cm to 8cm.
If you do not know the difference, and wish to have an aquarium size of moss ball "faster", this is not the one you want.